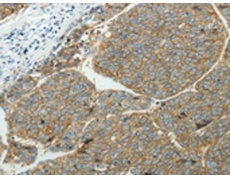
一抗

中文名稱:兔抗SLC16A1多克隆抗體
英文名稱: Anti-SLC16A1 rabbit polyclonal antibody
別 名: MCT, HHF7, MCT1
相關(guān)類別: 一抗
儲 存: 冷凍(-20℃)
宿 主: Rabbit
抗 原: SLC16A1
反應(yīng)種屬: Human
標(biāo)記物: Unconjugate
克隆類型: rabbit polyclonal
技術(shù)規(guī)格
|
Background: |
The protein encoded by this gene is a proton-linked monocarboxylate transporter that catalyzes the movement of many monocarboxylates, such as lactate and pyruvate, across the plasma membrane. Mutations in this gene are associated with erythrocyte lactate transporter defect. Alternatively spliced transcript variants have been found for this gene. |
|
Applications: |
ELISA, IHC |
|
Name of antibody: |
SLC16A1 |
|
Immunogen: |
Synthetic peptide of human SLC16A1 |
|
Full name: |
Solute carrier family 16, member 1 (monocarboxylic acid transporter 1) |
|
Synonyms: |
MCT, HHF7, MCT1 |
|
SwissProt: |
P53985 |
|
ELISA Recommended dilution: |
2000-10000 |
|
IHC positive control: |
Human liver cancer and Human ovarian cancer |
|
IHC Recommend dilution: |
50-200 |

 購物車
購物車 幫助
幫助
 021-54845833/15800441009
021-54845833/15800441009